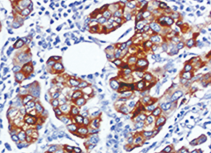

pS2抗体试剂
pS2抗体试剂
产品描述
pS2抗体是一种特异性识别雌激素调节蛋白pS2(又称TFF1)的免疫检测工具,该蛋白属于三叶因子家族,在胃肠道黏膜保护和修复中起重要作用。在乳腺癌分子分型中,pS2抗体的核阳性表达(常与ER/PR检测联合应用)提示肿瘤具有雌激素依赖性特征,对内分泌治疗敏感性预测具有辅助价值。值得注意的是,pS2在胃癌(尤其是肠型胃癌)和结肠癌中也可异常表达,其表达水平与肿瘤分化程度和预后相关,为消化系统肿瘤的研究提供了新的分子标记。
参考文献
产品信息
备案名称:
pS2抗体试剂
备案证号:
粤深械备 20221694
产品型号:
DMRD0251
适用:
阳性部位:
细胞质
预 处 理:
EDTA 热修复
产品规格
| 类型 | 即用型 | 浓缩型 | ||||
| 规格 | 1ml | 3ml | 6ml | 10ml | 0.1ml | 0.2ml |


